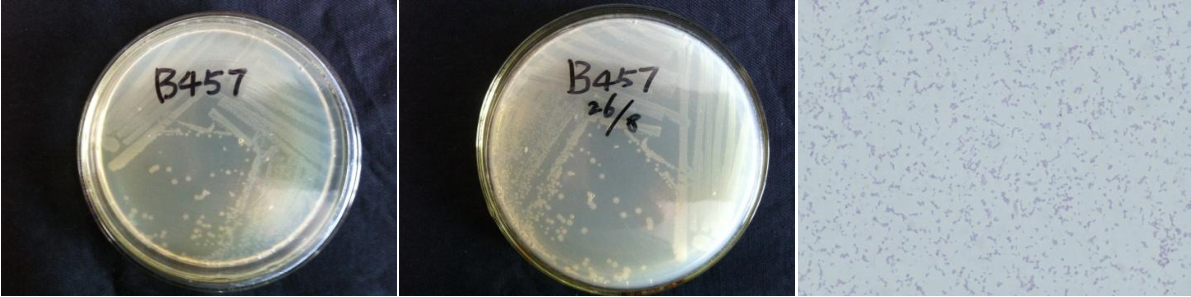

Loading...
| StrainNO | B457 |
| Classification | Cupriavidus |
| 16s rDNA sequence | CGGGGCCGGTGGGGTAGCGCCCTCCTTGCGGTTAGGCTACCTACTTCTGGCAAAACCCACTCCCATGGTGTGACGGGCGGTGTGT ACAAGACCCGGGAACGTATTCACCGCGGCATGCTGATCCGCGATTACTAGCGATTCCAGCTTCACGTAGTCGAGTTGCAGACTAC GATCCGGACTACGATGCGTTTTCTGGGATTAGCTCCCCCTCGCGGGTTGGCAACCCTCTGTACGCACCATTGTATGACGTGTGAA GCCCTACCCATAAGGGCCATGAGGACTTGACGTCATCCCCACCTTCCTCCGGTTTGTCACCGGCAGTCTCTCTAGAGTGCCCTTG CGTAGCAACTAGAGACAAGGGTTGCGCTCGTTGCGGGACTTAACCCAACATCTCACGACACGAGCTGACGACAGCCATGCAGCAC CTGTGTCCACTTTCCCTTTCGGGCACCTGATGCATCTCTGCTTCGTTAGTGGCATGTCAAGGGTAGGTAAGGTTTTTCGCGTTGC ATCGAATTAATCCACATCATCCACCGCTTGTGCGGGTCCCCGTCAATTCCTTTGAGTTTTAATCTTGCGACCGTACTCCCCAGGC GGTCAACTTCACGCGTTAGCTACGTTACTGAAGAAATGAATCCCCAACAACTAGTTGACATCGTTTAGGGCGTGGACTACCAGGG TATCTAATCCTGTTTGCTCCCCACGCTTTCGTGCATGAGCGTCAGTGACGTCCCAGGGGGCTGCCTTCGCCATCGGTATTCCTCC ACATCTCTACGCATTTCACTGCTACACGTGGAATTCTACCCCCCTCTGACATACTCTAGCCTTGCAGTCACAAGCGCCATTCCCA AGTTGAGCTCGGGGATTTCACGCCTGTCTTACAAAACCGCCTGCGCACGCTTTACGCCCAGTAATTCCGATTAACGCTCGCACCC TACGTATTACCGCGGCTGCTGGCACGTAGTTAGCCGGTGCTTATTCTTCCGGTACCGTCATCCACGCCGGGTATTAACCAGCGCG TTTTCTTTCCGGACAAAAGTGCTTTACAACCCGAAGGCCTTCTTCACACACGCGGCATTGCTGGATCAGGGTTGCCCCCATTGTC CAAAATTCCCCACTGCTGCCTCCCGTAGGAGTCTGGGCCGTGTCTCAGTCCCAGTGTGGCTGATCGTCCTCTCAGACCAGCTACT GATCGTCGCCTTGGTAGGCCTTTACCCCACCAACTAGCTAATCAGACATCGGCCGCTCCTATTGCGCGAGGCCTTGCGGTCCCCC GCTTTCACCCTCAGGTCGTATGCGGTATTAGCTAATCTTTCGACTAGTTATCCCCCACAACAGGGCACGTTCCGATGTATTACTC ACCCGTTCGCCACTCGCCGCCAGGCCGAAGCCCGCGCTGCCGTCGACTGCCCATGGTAAGGCAGCCGCCCC |
| Strain Morphology Photos | |
| Morphological Description | Colony round;clam white;flat;edge neatly;slippy;sticky;translucent;Bacteriophage Rod-shaped;no spore |